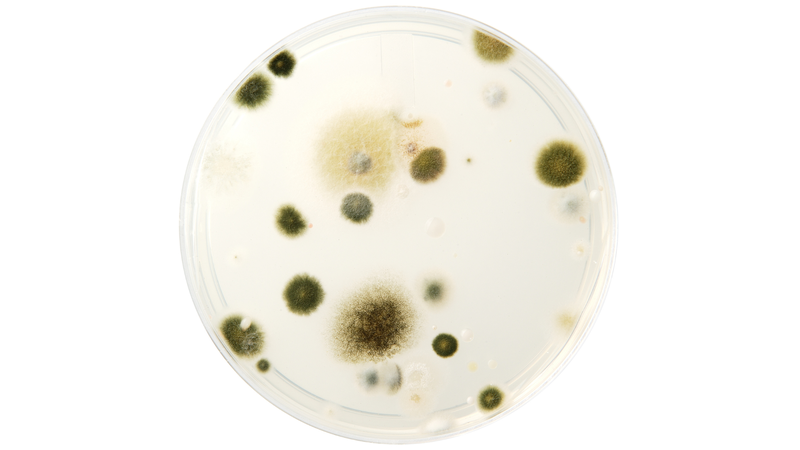
Hình ảnh khuẩn lạc nấm mốc
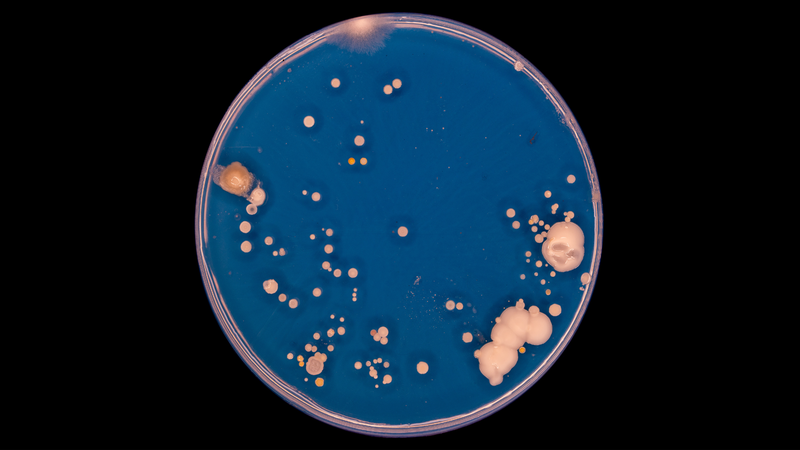
Đếm số lượng khuẩn lạc bằng cách quan sát trên đĩa Petri
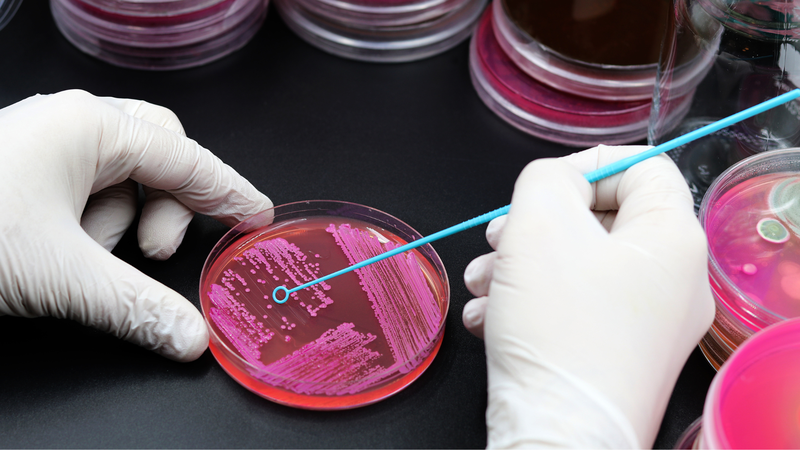
Khuẩn lạc đóng vai trò quan trọng trong nghiên cứu vi sinh học

Từng làm ở Viện ISDS, nhiều năm cộng tác với CDC Thái Nguyên triển khai dự án phòng chống HIV/AIDS, 2 năm cộng tác với WHO.
Kim Toàn
19/09/2025
Mặc định
Lớn hơn
Khuẩn lạc là gì? Đây là một khái niệm nền tảng nhưng giữ vai trò quan trọng trong lĩnh vực vi sinh. Việc nắm vững đặc điểm của khuẩn lạc, cũng như cách nhận diện và định lượng chúng, giúp quá trình nghiên cứu, chẩn đoán và ứng dụng trong sản xuất sinh học đạt hiệu quả cao hơn. Hãy cùng khám phá chi tiết về khuẩn lạc qua nội dung sau!
Trong vi sinh vật học, việc nghiên cứu các vi sinh vật như vi khuẩn, nấm, virus hay động vật nguyên sinh không chỉ dừng lại ở việc quan sát cấu trúc hay hoạt động sinh lý của chúng, mà còn cần đến các kỹ thuật nuôi cấy để hình thành nên khuẩn lạc. Đây là tập hợp các tế bào vi sinh vật phát triển từ một tế bào ban đầu hoặc một nhóm tế bào đồng nhất, có thể nhìn thấy bằng mắt thường trên môi trường nuôi cấy. Vậy khuẩn lạc là gì và hiện nay có những loại khuẩn lạc nào thường gặp trong phòng thí nghiệm vi sinh?
Khuẩn lạc là gì? Trong vi sinh vật học, khuẩn lạc (hay còn gọi là colony) là một nhóm vi sinh vật, thường là vi khuẩn hoặc nấm, phát triển từ một tế bào gốc duy nhất trên môi trường nuôi cấy rắn. Khi tế bào gốc này phân chia, chúng tạo thành một khối lượng có thể nhìn thấy bằng mắt thường, gọi là khuẩn lạc. Mỗi khuẩn lạc đại diện cho một chủng vi sinh vật duy nhất, giúp phân biệt và xác định các loài khác nhau trong mẫu thử.
Khuẩn lạc có thể có hình dạng, kích thước, màu sắc và kết cấu bề mặt khác nhau, tùy thuộc vào loại vi sinh vật và điều kiện môi trường. Việc quan sát và mô tả các đặc điểm này được gọi là hình thái khuẩn lạc (colony morphology), là bước đầu tiên trong quá trình nhận dạng vi sinh vật.

Đặc điểm:
Ví dụ phổ biến:
Đặc điểm:
Ví dụ phổ biến:
Đặc điểm:
Ví dụ phổ biến:
Đặc điểm:
Ví dụ phổ biến: Streptomyces khuẩn lạc trắng kem, có mùi đất đặc trưng.
Trong vi sinh học, khuẩn lạc thường được định lượng bằng hai đơn vị cơ bản:
So sánh CFU và MPN:
Mặc dù cách đo khác nhau, CFU và MPN đều được công nhận trên toàn cầu bởi các tổ chức khoa học và quản lý uy tín như EPA (Cơ quan Bảo vệ Môi trường Hoa Kỳ) và ISO (Tổ chức Tiêu chuẩn hóa Quốc tế).
Các phương pháp đếm và quan sát khuẩn lạc phổ biến hiện nay là:
Khuẩn lạc là tập hợp các tế bào vi sinh vật phát triển từ một tế bào gốc duy nhất trên môi trường nuôi cấy, và chúng đóng vai trò cực kỳ quan trọng trong nghiên cứu vi sinh học cũng như trong các ứng dụng y học, công nghiệp và thực phẩm.
Việc nghiên cứu khuẩn lạc cho phép các nhà khoa học phân lập, nhận dạng, phân loại và kiểm tra các vi sinh vật trong nhiều môi trường khác nhau, từ đó giúp nâng cao hiểu biết về sinh lý, độc tính và tiềm năng ứng dụng của từng loại vi sinh vật.
Ngoài các ứng dụng trong y học, khuẩn lạc còn đóng vai trò quan trọng trong nghiên cứu môi trường và công nghiệp thực phẩm. Chẳng hạn, khuẩn lạc Lactobacillus và Bifidobacterium được dùng để sản xuất các sản phẩm sữa lên men và thực phẩm chức năng, giúp cải thiện hệ vi sinh đường ruột và sức khỏe tiêu hóa. Trong khi đó, khuẩn lạc Pseudomonas và Acinetobacter được nghiên cứu để phát triển các phương pháp xử lý chất thải, phân hủy chất độc hại hoặc sinh tổng hợp các hợp chất có ích trong công nghiệp.
Việc phân lập và nghiên cứu khuẩn lạc còn hỗ trợ phân tích độc lực và nguy cơ gây bệnh của các vi sinh vật, từ đó thiết lập các phương pháp phòng ngừa và kiểm soát dịch bệnh hiệu quả. Ví dụ, khuẩn lạc Vibrio parahaemolyticus giúp xác định các chủng vi khuẩn gây bệnh đường ruột, đồng thời hỗ trợ kiểm tra an toàn thực phẩm hải sản. Tương tự, khuẩn lạc Salmonella và Listeria monocytogenes cũng được theo dõi để phòng tránh ngộ độc thực phẩm và dịch bệnh.
Như vậy, qua bài viết này chúng ta đã hiểu rõ hơn khuẩn lạc là gì, cũng như những đặc điểm và một số loại khuẩn lạc phổ biến thường gặp trong nghiên cứu vi sinh. Việc nhận diện và phân loại khuẩn lạc không chỉ giúp các nhà khoa học chẩn đoán, theo dõi vi sinh vật mà còn đóng vai trò quan trọng trong y học, công nghệ sinh học và an toàn thực phẩm.
Dược sĩ Đại học Nguyễn Tuấn Trịnh
Từng làm ở Viện ISDS, nhiều năm cộng tác với CDC Thái Nguyên triển khai dự án phòng chống HIV/AIDS, 2 năm cộng tác với WHO.